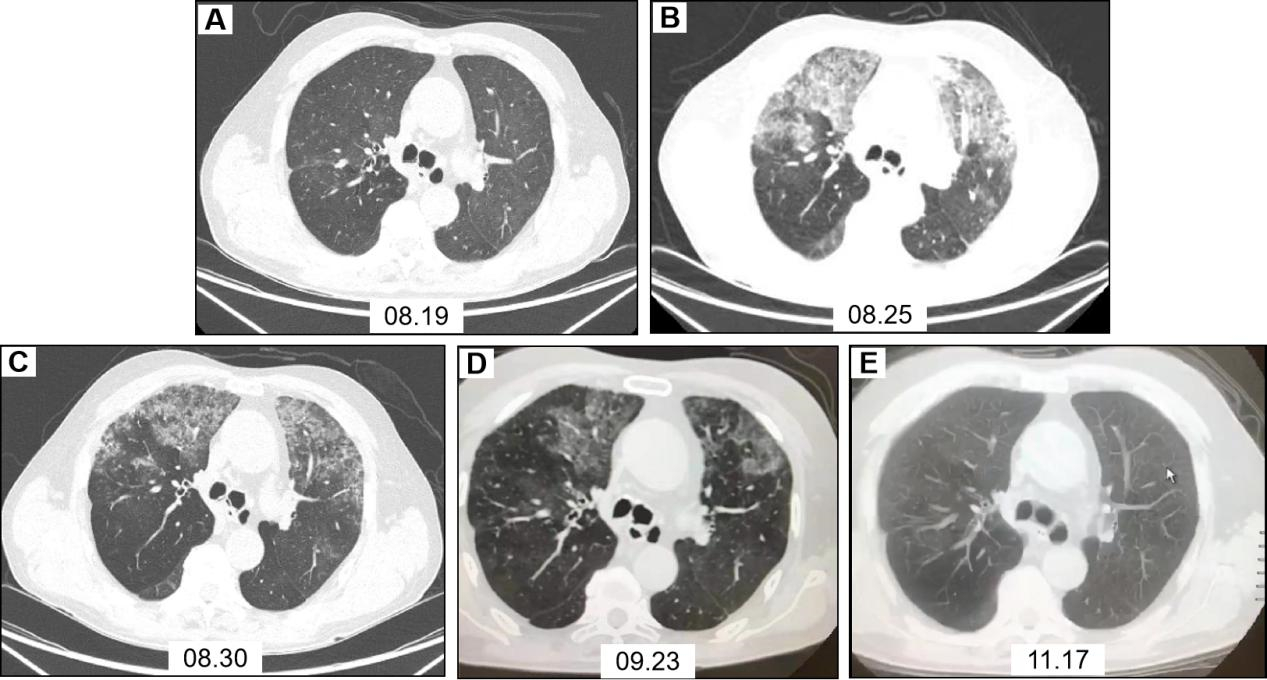

患者,男,64岁,2020-08-19因“胸闷4 d,加重11 h”入院。患者4 d前受凉后出现活动后胸闷、气喘,间断咳嗽、咳痰,于家中自行静脉应用抗感染、舒张支气管、化痰等药物治疗。11 h前误将石蜡油20 mL静脉注射,立即出现持续性胸闷、气喘,剧烈咳嗽,持续约20 min后症状较前稍减轻,至“漯河市中心医院”就诊,给予对症治疗(具体不详),症状无明显减轻,遂来本院。入院查体:体温36.5℃,脉搏86次/min,呼吸20次/min,血压122/80 mmHg(1 mmHg=0.133 kPa),呼吸室内空气氧饱和度88%,左肺吸气相可闻及湿啰音。动脉血气分析(室内静息状态未吸氧):PO2 57.9 mmHg,PCO2 45 mmHg。白细胞13.23×109/L,中性粒细胞10.88×109/L,中性粒细胞百分数82.2%,C反应蛋白16.28 g/L,PCT 0.117 ng/mL。胸部CT(2020-08-19,图 1A)示双肺支气管扩张并感染,左肺为著;双肺胸膜下微小炎性结节考虑。肺动脉CTA,肠系膜动脉CTA及头颅MRA未见动脉栓塞。立即给予吸氧、莫西沙星抗感染、甲强龙抗炎、低分子肝素抗凝、脂肪乳、舒张支气管、化痰等治疗,并分别于入院后16 h、48 h行2次血浆置换。治疗后患者自觉症状减轻,鼻导管吸氧2 L/min,氧饱和度持续 > 94%。入院第3天患者胸闷气喘较前加重,鼻导管吸氧4 L/min,动脉血气分析:PO2 57.8 mmHg,PCO2 58.7 mmHg。给予面罩给氧,增大氧流量,吸氧6 L/min,氧饱和度可维持 > 94%。复查胸部CT(2020-08-25,图 1B)示双上肺絮状高密度影,局部呈磨玻璃样改变。支气管镜示:主气管见大量陈旧性血性粘痰,右上叶、中叶段支气管见大量陈旧性血性分泌物,左上叶可见中等量稀薄分泌物、左下叶段支气管见大量稀薄分泌物。右上叶支气管毛刷涂片细胞学示:镜下见中等量纤毛柱状上皮细胞(图 2A)。右上叶肺泡灌洗液涂片细胞学示:镜下见少量上皮细胞、吞噬细胞及炎细胞(图 2B、图 2C)。肺功能示:重度阻塞性为主的混合型通气功能障碍,肺总量降低,肺活量降低,残气/肺总量%增高,支气管舒张试验阳性。继续给予抗感染、抗炎、抗凝及对症治疗,患者症状逐渐减轻,复查肺部CT较前好转(2020-08-30,图 1C),激素逐渐减量,好转出院。于出院后1个月(2020-09-23,图 1D),3个月(2020-11-17,图 1E)复查胸部CT,双肺病灶逐渐好转,随访1年,患者恢复良好。
|
| 图 1 患者治疗前后胸部CT影像 |
|
|

|
| A:右上叶支气管刷检(巴氏× 400);B、C:右上叶肺泡灌洗液涂片(HE× 400) 图 2 患者细胞学染色图 |
|
|
本病例为意外静脉注射石蜡油,静脉注射油类物质国内外仅有少数病例报道,大部分会导致肺部炎症,呼吸衰竭,也有病例出现急性呼吸窘迫综合征需有创机械通气或ECMO治疗[1]。还有报道表明静脉注射油类物质后会出现肝肾功能损伤,全身炎症反应综合,脓毒症,甚至多脏器功能衰竭,但预后一般较好,个别会死于多脏器功能衰竭[2]。
既往有病例报道称静脉注射油类物质所致肺炎为脂质性肺炎,肺泡灌洗液中可见泡沫状、富含脂质的肺泡巨噬细胞[1]。脂质性肺炎报道更多见于吸入油类物质所致的肺部病变。本病例行气管镜肺泡灌洗液细胞学检查见少量上皮细胞、吞噬细胞及炎细胞,与脂质性肺炎的细胞学表现并不相符。可见,静脉注射油类物质所致的肺部病变并不一定是脂质性肺炎,其病理生理机制异于吸入油类物质,与脂肪栓塞综合征更为类似。1974年Hausberger等[3]用矿物油对实验大鼠进行股静脉注射模拟脂肪栓塞综合征模型,结果显示注射矿物油后,肺组织病理学改变主要包括血管周围水肿、出血和浸润;肺泡间隙和小支气管出血;肺泡细胞的分解和死亡,这些变化在注射后第1天明显,第3、4天达高峰,第9天水肿减轻,出血浸润仍明显,第20天,大面积的肺表现正常,与本病例病程相似。目前脂肪栓塞综合征导致肺功能障碍的机制存在两种理论[1]:一为生化理论,油脂沉积于肺毛细血管刺激局部炎症因子释放,血管内皮受损,血管通透性增加,油脂渗透入肺泡内导致肺泡内渗出出血,受损的肺血管内皮细胞可触发促炎细胞因子级联反应。另外油类物质对肺实质细胞、毛细血管内皮细胞及肺泡表面活性物质有直接毒性作用。二为机械理论,油脂进入静脉后随血液循环阻塞肺毛细血管,导致通气血流比例下降。但本病例肺动脉CTA并未发现肺动脉阻塞征象,考虑可能因为油类物质CT下不显影、油脂小分子沉积于肺毛细血管并未阻塞肺大血管或油类物质进入肺血管后引起血管反应性痉挛并未完全堵塞血管。
本病例静脉注射石蜡油后立即出现胸闷、气喘、剧烈咳嗽,随后症状稍缓解,入院时胸部CT并无脂肪栓塞综合征类似肺部表现。4 d后胸闷症状较前加重,复查胸部CT出现双肺絮状高密度影,既往病例报道也有类似肺部延迟性病变报道[4-5]。胸部CT示局部呈磨玻璃样改变,双上肺及外周病变较重,与既往报道静脉注射油类物质所致肺部影像学表现类似[5]。其病理生理过程可能为油类物质注射入外周静脉后立即随血液循环经腔静脉入右心房,随后进入肺循环,沉积于肺毛细血管,导致机械阻塞,通气血流比例下降,即刻出现症状,但尚未出现肺部影像学改变;后局部炎症因子释放,血管内皮细胞受损,血管通透性增加,肺泡内渗出出血,表现为数天后症状加重,肺部影像出现渗出及磨玻璃样改变。因油类物质不溶于血液,较血液轻,并沉积于肺外周毛细血管,因此肺部CT表现以双上肺及外周病变较重。
本病例入院后体温最高38.5 ℃,CRP等炎症指标升高,入院早期给予血浆置换及糖皮质激素抗炎应用,第一次血浆置换后患者体温未再升高,咳嗽、胸闷等症状较前明显减轻。静脉注射石蜡油早期进行血液净化可清除血液内油类物质及炎症因子,以往有血液净化应用于静脉注射液体石蜡治疗成功的报道[6],考虑相较于吸入所致脂质性肺炎,静脉注射油脂类物质,早期应用血液净化治疗较肺泡内灌洗意义更大。其次,糖皮质激素可减轻局部炎症因子释放,减轻油类物质对细胞的直接毒性作用,稳定溶酶体膜,降低毛细血管通透性,减轻肺间质水肿[7]。此外,有研究表明肝素能够增加血液脂肪酶的活性,帮助清除血液中脂肪粒;提高表面生长因子生物活性,维持肺泡壁的完整性,有利于肺水的清除,可缓解胸闷症状[8]。另外有研究发现,脂肪乳剂可减轻多种亲脂类物质的毒性,起到辅助解毒的作用。
综上所述,静脉注射油类物质以呼吸系统症状为主,多表现为肺部炎症及呼吸功能障碍。病理生理机制可能为机械阻塞及生化损伤。症状及肺部影像学表现有延迟现象。早期血液净化可能较肺泡内灌洗意义更大,需要呼吸功能支持,早期糖皮质激素抗炎、抗凝、脂肪乳、抗感染及对症治疗等综合治疗,多数预后较好。
利益冲突 有作者声明无利益冲突
本文有附录,可登录中华急诊网(www.cem.org.cn)浏览本文(Html格式全文)
| [1] | Pasgaard T, Huynh ANT, Gjedsted J. Extracorporeal membrane oxygenation after intravenous injection of paraffin oil[J]. Perfusion, 2016, 31(8): 706-708. DOI:10.1177/0267659116646180 |
| [2] | Houben MH, Drent M, Jacobs JA, et al. Multiple organ dysfunction syndrome (MODS) after an intravenous injection of lamp oil (liquid paraffin)[J]. Intensive Care Med, 1998, 24(1): 87-88. DOI:10.1007/pl00003760 |
| [3] | Hausberger FX, Phelan TI. Pulmonary free fatty acids in experimental mineral oil embolism[J]. The Journal of Trauma, 1974, 14(11): 950-954. DOI:10.1097/00005373-197411000-00007 |
| [4] | Kiyokawa H, Utsumi K, Minemura K, et al. Fat embolism syndrome caused by vegetable oil injection[J]. Intern Med, 1995, 34(5): 380-383. DOI:10.2169/internalmedicine.34.380 |
| [5] | Hjort M, Hoegberg LC, Almind M, et al. Subacute fat-embolism-like syndrome following high-volume intramuscular and accidental intravascular injection of mineral oil[J]. Clin Toxicol (Phila), 2015, 53(4): 230-232. DOI:10.3109/15563650.2015.1013195 |
| [6] | 马颖, 杨明施, 万齐全, 等. 成功救治意外静脉注射液体石蜡一例并文献复习[J]. 临床误诊误治, 2009, 22(8): 29-30. DOI:10.3969/j.issn.1002-3429.2009.08.018 |
| [7] | 李永顺, 刘鸿博. 创伤性脑型脂肪栓塞的诊治分析[J]. 中国伤残医学, 2014, 22(4): 82-83. DOI:10.13214/j.cnki.cjotadm.2014.04.060 |
| [8] | 付潇潇, 刘群, 耿辉. 低分子肝素联合表皮细胞生长因子对吸入性损伤大鼠肺治疗效果的研究[J]. 中华损伤与修复杂志(电子版), 2009, 4(5): 532-537. DOI:10.3969/j.issn.1673-9450.2009.05.006 |
 2023, Vol. 32
2023, Vol. 32




